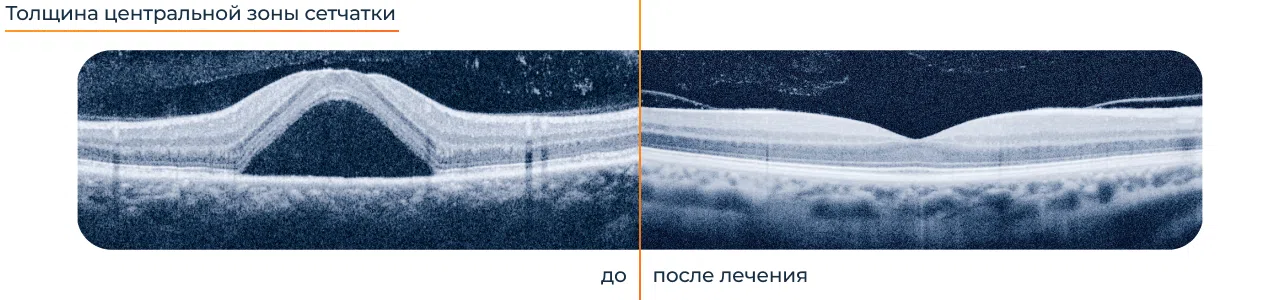
Методы лечения фиброза сетчатки

Эпиретинальный фиброз
Эпиретинальный фиброз (ЭФР) — это заболевание сетчатки глаза, при котором на ее внутренней поверхности образуется тонкая мембрана или пленка из рубцовой (фиброзной) ткани. Она постепенно стягивает оболочку, вызывая ее деформацию, образование складок и отек. Поскольку чаще всего мембрана поражает область макулы, состояние сопровождается выраженными зрительными нарушениями.
Причины и факторы риска
В большинстве случаев фиброз глаза является идиопатическим, то есть возникает без очевидной причины, преимущественно у людей старше 50 лет. Возможными причинами вторичного поражения могут быть:
- деструкция стекловидного тела глаза и его задняя отслойка (ЗОСТ);
- воспалительные заболевания: увеит, ретинит;
- сосудистые патологии: окклюзия (закупорка) центральной вены сетчатки или ее ветвей, диабетическая ретинопатия;
- травмы глаз, операции на них.

Факторами риска являются вредные привычки: курение, неправильное питание, приводящее к избытку холестерина в крови и развитию атеросклероза.
Патогенез заболевания до сих пор неизвестен. Считается, что в основе лежит частичное отслоение задней мембраны стекловидного тела и сращение ее с макулой. В результате происходит натяжение (тракция) ткани, которое, в свою очередь, запускает процессы регенерации и приводит к формированию мембраны. Она вызывает появление морщин и складок оболочки, нарушает ее нормальное строение, ухудшая восприятие световых лучей.
Классификация
В зависимости от происхождения выделяют идиопатический и вторичный эпиретинальный фиброз. В течении идиопатической формы заболевания различают 4 стадии.
- Пленка тонкая, все слои сетчатки четко дифференцируются, макулярная ямка хорошо видна.
- Отмечается сглаженность макулярной ямки и расширение наружного слоя сетчатки.
- Ямка отсутствует, слои начинают сливаться между собой.
- Полная дезорганизация слоев сетчатки.
Классификация по стадиям позволяет объективно оценить тяжесть патологического процесса, принять решение о необходимости хирургического вмешательства и оценить прогноз для пациента.
Симптомы фиброза сетчатки глаза

На ранних стадиях заболевание может протекать бессимптомно, однако по мере сморщивания и уплотнения пленки возникают характерные зрительные нарушения.
- искажение прямых линий (метаморфопсии), когда предметы кажутся изогнутыми или волнистыми;
- затуманивание зрения и снижение его остроты, сложности с чтением мелкого текста;
- появление серого пятна или полупрозрачной «шторки» в центральной части поля зрения;
- трудности с распознаванием мелких деталей и лиц;
- избыточная чувствительность к свету;
- быстрое утомление глаз при зрительной нагрузке.
Выраженность симптомов напрямую зависит от стадии заболевания и степени тракции. Появление любого из этих признаков — это повод для незамедлительного обращения к офтальмологу и проведения детальной диагностики. Если патология прогрессирует, центральное зрение пациента ухудшается все сильнее, могут возникнуть признаки разрыва и отслойки сетчатки.
Осложнения фиброза сетчатки

При отсутствии адекватного лечения прогрессирующий эпиретинальный фиброз может привести к осложнениям. Их развитие связано с продолжающимся натяжением сетчатки, которое, в свою очередь, приводит к тяжелому повреждению ткани:
- формирование стойкого макулярного отека вследствие нарушения проницаемости сосудов;
- развитие макулярного разрыва — сквозного дефекта в центральной зоне оболочки;
- локальная или распространенная отслойка сетчатки, вызванная ее сильным натяжением;
- гибель фоторецепторов и нарушение восприятия световых лучей.
Осложнения угрожают полной и необратимой потерей центрального зрения. Своевременная диагностика и лечение позволяют минимизировать риск и сохранить зрительную функцию.
Диагностика

Основная задача диагностики — подтвердить наличие мембраны, оценить ее плотность, степень тракции и вызванные ею структурные изменения сетчатки. Обследование начинается со сбора жалоб и анамнеза, в ходе которых врач выявляет характерные симптомы, отмечает динамику их развития, выделяют провоцирующие факторы. Окончательный диагноз ставится по результатам комплексного офтальмологического обследования. В него входят:
- визометрия для определения степени снижения остроты зрения;
- периметрия для оценки состояния поля зрения, обнаружения слепых пятен;
- тест с решеткой Амслера для выявления метаморфопсий;
- офтальмоскопия для визуальной оценки поверхности сетчатки и обнаружения характерной для фиброза пленки;
- оптическая когерентная томография (ОКТ), которая позволяет детально визуализировать мембрану, оценить ее размеры, исследовать слои сетчатки и степень деформации оболочки;
- флюоресцентная ангиография для оценки состояния сосудов и выявления отека макулы.
В качестве дополнительного метода диагностики может использоваться УЗИ, которое особенно информативно при недостаточной прозрачности глазных сред, например, при сопутствующей катаракте. По необходимости назначаются консультации специалистов смежного профиля, проводятся анализы крови и другие исследования для выявления фоновых процессов.
Методы лечения
Тактика лечения фиброза сетчатки глаза зависит от его причины, стадии и выраженности симптомов. На начальном этапе, когда мембрана тонкая и не вызывает значительного снижения зрения, достаточно динамического наблюдения. Пациент регулярно посещает врача, проходит обследование для оценки состояния сетчатки.
При прогрессировании заболевания и возникновении зрительных нарушений основным методом лечения является хирургическое вмешательство — витрэктомия. В ходе операции производится удаление стекловидного тела и последующее отделение фиброзной мембраны от поверхности сетчатки с помощью микрохирургических инструментов. Эта процедура позволяет расправить оболочку и предотвратить ее повторную деформацию. При разрывах или отслойках, а также при высоком риске их развития проводится профилактическая лазерная коагуляция.
Прогноз зависит от давности заболевания и выраженности структурных изменений в сетчатке. При своевременном лечении острота зрения значительно улучшается. При позднем обращении поражение становится необратимым.
Профилактика фиброза сетчатки
Специфической профилактики, направленной непосредственно на предотвращение образования эпиретинальной мембраны, нет, поскольку не всегда удается четко отследить причину заболевания. Основные усилия должны быть сосредоточены на контроле над системными патологиями, которые являются факторами риска. Эффективное лечение сахарного диабета и артериальной гипертензии позволяет значительно снизить вероятность развития сосудистых осложнений, способных запустить процесс фиброза.

Наиболее важной мерой является регулярное прохождение офтальмологических осмотров. Это особенно актуально для лиц старше 50 лет и пациентов с уже диагностированными заболеваниями сетчатки. Своевременная диагностика задней отслойки стекловидного тела, разрывов и других патологий позволяет вовремя провести операцию и предотвратить необратимые изменения.
FAQ
Влияет ли эпиретинальный фиброз на оба глаза?
Патология обычно носит односторонний характер. Однако в ряде случаев, особенно на фоне системных патологий (например, диабета), существует риск появления фиброза и на втором глазу.
Можно ли полностью вылечить эпиретинальный фиброз?
Да. После операции витрэктомии с удалением эпиретинальной мембраны анатомия и функции сетчатки восстанавливаются. Вероятность рецидива минимальна.
Как быстро прогрессирует эпиретинальный фиброз?
Скорость прогрессирования индивидуальна. У некоторых пациентов мембрана годами остается стабильной, у других — быстро уплотняется и вызывает выраженное снижение зрения за несколько месяцев.
Бывают ли случаи заболевания у детей и подростков, или оно характерно только для взрослых?
Эпиретинальный фиброз крайне редко развивается в детском возрасте и у подростков. Это заболевание характерно преимущественно для лиц старше 50 лет.
Можно ли заниматься спортом при эпиретинальном фиброзе?
Рекомендуется избегать видов спорта, связанных с резкими сотрясениями, прыжками и подъемом тяжестей, так как это может усилить натяжение сетчатки и спровоцировать осложнения. Перед началом занятий необходимо обратиться в отделение офтальмологии, врач объяснит, что такое ЭФР и какие ограничения накладывает это заболевание.
Источники
- Арсютов Д.Г. Клинические варианты эпиретинального «фиброза» (предварительное сообщение). Восток — Запад. Точка зрения. № 1. 2014.
- Кочергин С. А., Алипов Д. Г. Хирургическое лечение эпимакулярного фиброза. Современное состояние проблемы // РМЖ. Клиническая офтальмология. 2018. №1.
- Захаров В. Д., Борзенок С. А., Горшков И. М., Колесник С. В., Колесник А. И., Миридонова А. В. Этиопатогенетические аспекты и роль структур витреоретинального интерфейса в формировании идиопатических эпиретинальных мембран // ПМ. 2018. №3.
- Тахчиди Х. П., Качалина Г. Ф., Касмынина Т. А., Тебина Е. П. Современные аспекты мультимодальной диагностики идиопатической эпиретинальной мембраны // Вестник РГМУ. 2017. №5.











